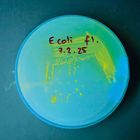

Reflecting Oil, Flexibler Einband
Reflecting Oil
- Herausgeber:
- Ernst Logar
- Verlag:
- Walter de Gruyter, 06/2025
- Einband:
- Flexibler Einband
- Sprache:
- Englisch
- ISBN-13:
- 9783689242534
- Artikelnummer:
- 12509810
- Umfang:
- 144 Seiten
- Gewicht:
- 838 g
- Maße:
- 299 x 226 mm
- Stärke:
- 19 mm
- Erscheinungstermin:
- 2.6.2025
- Serie:
- Edition Angewandte
- Hinweis
-
Achtung: Artikel ist nicht in deutscher Sprache!
Klappentext
Die Buchreihe der Universität für angewandte Kunst Wien, Edition Angewandte, von Rektor emeritus Dr. Gerald Bast ins Leben gerufen, erscheint je nach Thema in den Verlagen Birkhäuser und De Gruyter. Sie umfasst Sammelbände, Dokumentationen und Monografien aus den Bereichen Architektur, Bildende und Mediale Kunst, Design, Konservierung und Restaurierung, Kunstwissenschaften, Kunstpädagogik, Kunstvermittlung sowie Sprachkunst. Seit ihrer Gründung im Jahr 2007 hat sich die Reihe als bedeutende Plattform für relevante Veröffentlichungen an der Schnittstelle von Kunst und Wissenschaft etabliert. Die Bücher erscheinen in deutscher wie auch in englischer Sprache.